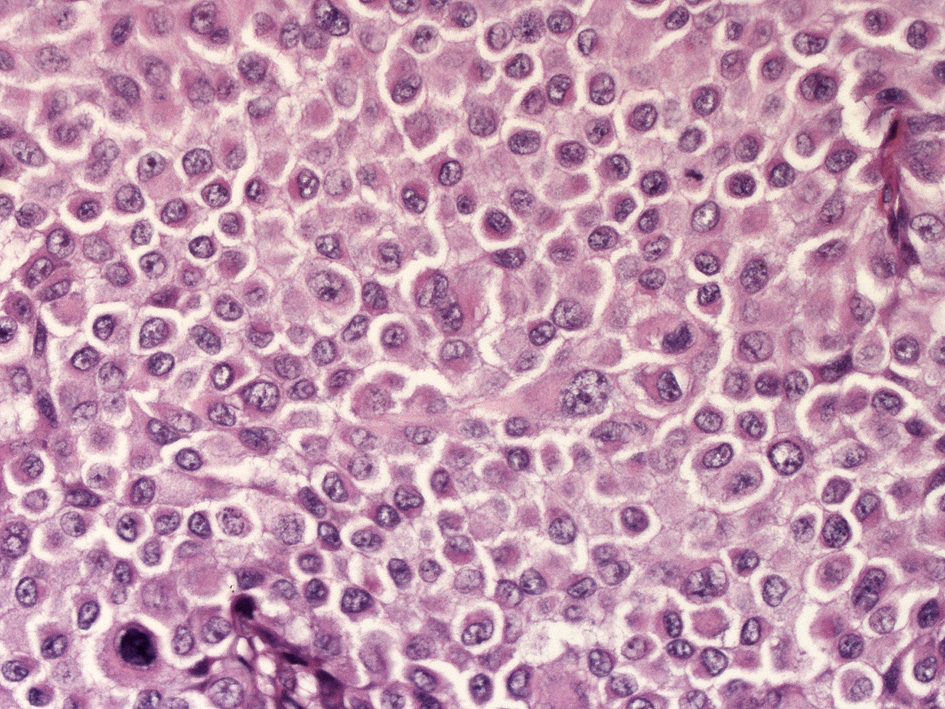

Melanoma 悪性黒色腫
melanoma 悪性黒色腫
Sorry; このページの画像, VS閲覧にはID, passwordが必要です。
Case: 結節型悪性黒色腫†
66years-old female 頭皮。
 HE lpf
HE lpf
HE x400
HE x400
- 通常は結節型で, 6割の症例に潰瘍をともなう(自己発見が遅れるためと考えられる).
結節型悪性黒色腫の特徴
- 40歳代以降に好発し, 男性に多い。頭頸部, 体幹に多いが体のどこにでも発生する。
- 他の4亜型にくらべ垂直方向への増殖(垂直増殖期)が優位である。
- 他の4亜型にくらべ先行病変からではなくほとんどがde novoに発生する。
- 結節状, ポリープ状, あるいは有茎性の病変としてみられる。
- 組織学的に表皮内の水平方向への増殖はないか、あってもごくわずかである。
- 真皮内病巣は通常好酸性から淡明豊かな細胞質をもつ卵円形ないし円形の類上皮細胞から構成されている。細胞異型度と核分裂像は症例によりさまざま。
melanomaの免疫染色†
Melanocyte-associated markers
メラノーマ診断に頻用される抗体は:S-100, HMB-45(gp100), melanA/ MART-1の3種である。--->Melanocyte-specific markers
- S-100:S-100蛋白は単一の蛋白ではなく, 細胞内カルシウム代謝に重要なカルシウム結合蛋白の一群。
- S-100抗体は悪性黒色腫だけではなく, 皮膚では母斑やランゲルハンス細胞, 皮膚神経性腫瘍にも陽性となる。
- HMB45: 未熟なメラノゾームに存在する複合糖質のノイラミニダーゼ感受性オリゴ糖側鎖(gp-100)と反応する抗体。境界母斑や青色母斑と反応し, 胎児型メラノサイトとは種々な程度に反応する。
- HMB45:正常成人のメラノサイトと真皮内母斑は陰性である。
- melanA/ MART-1: 確診悪性黒色腫患者のT細胞が認識する主要関連抗原として同定された。メラノサイト系細胞に特異的であるが, HMB45とは対照的に良性母斑も陽性となる。
melanomaのステージ
皮膚悪性黒色腫melanomaは色素産生性の色素上皮細胞から発生する. 臨床的にはAmerican Joint Committee on Cancerのガイドラインをもちいてステージが決定される.*1
- 原発巣だけの患者(stage IとII)では, 腫瘍の厚さ(Breslow 腫瘍深達度,mm)と潰瘍形成が重要な予後因子.
- 所属リンパ節に限局する黒色腫は(stage III)では,
- リンパ節転移数とリンパ節転移の程度(ミクロ転移かマクロ転移か)
- リンパ節転移パターン;リンパ節, in-transit転移, あるいはその両方か)
- 原発巣の潰瘍化状態
- 遠隔転移をもつ悪性黒色腫(stage IV)では, 転移臓器, 血清LDH上昇の有無.
高リスクな特徴をもたない浸潤度の低い腫瘍の患者さん(stageI)の長期生存は95%以上.
遠隔転移陽性の患者(stageIV)では, 生存中央値は6-8ヵ月, 診断後5年生存率は10%未満である.
![[PukiWiki] [PukiWiki]](image/title-logo.png)
![[PukiWiki] [PukiWiki]](image/title-logo.png)